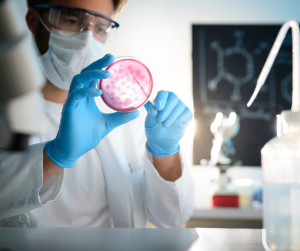

BESAT: Vi søger en laborant til vikariat 2 dage om ugen ca. 15 km. nord for Aarhus
De primære opgaver drejer sig om mikrobiologiske analyser på råvare, færdigvarer og produktionsmiljø.
Kandidat
Periode:
Arbejdstiden er som udgangspunkt følgende, men kan aftales
Er du laborant med erfaring i mikrobiologiske analyser og synes, at det lyder spændende, så send din ansøgning til katja@labvikar.dk
Vi indkalder løbende til samtaler i uge 5, så send gerne din ansøgning med det samme
Vi ønsker kun ansøgere med praktisk erfaring indenfor mikrobiologiske analyser !!
Husk at opdatere din profil ved LabVikar.
LabVikar ApS
Avernakøvænget 4
5000 Odense C